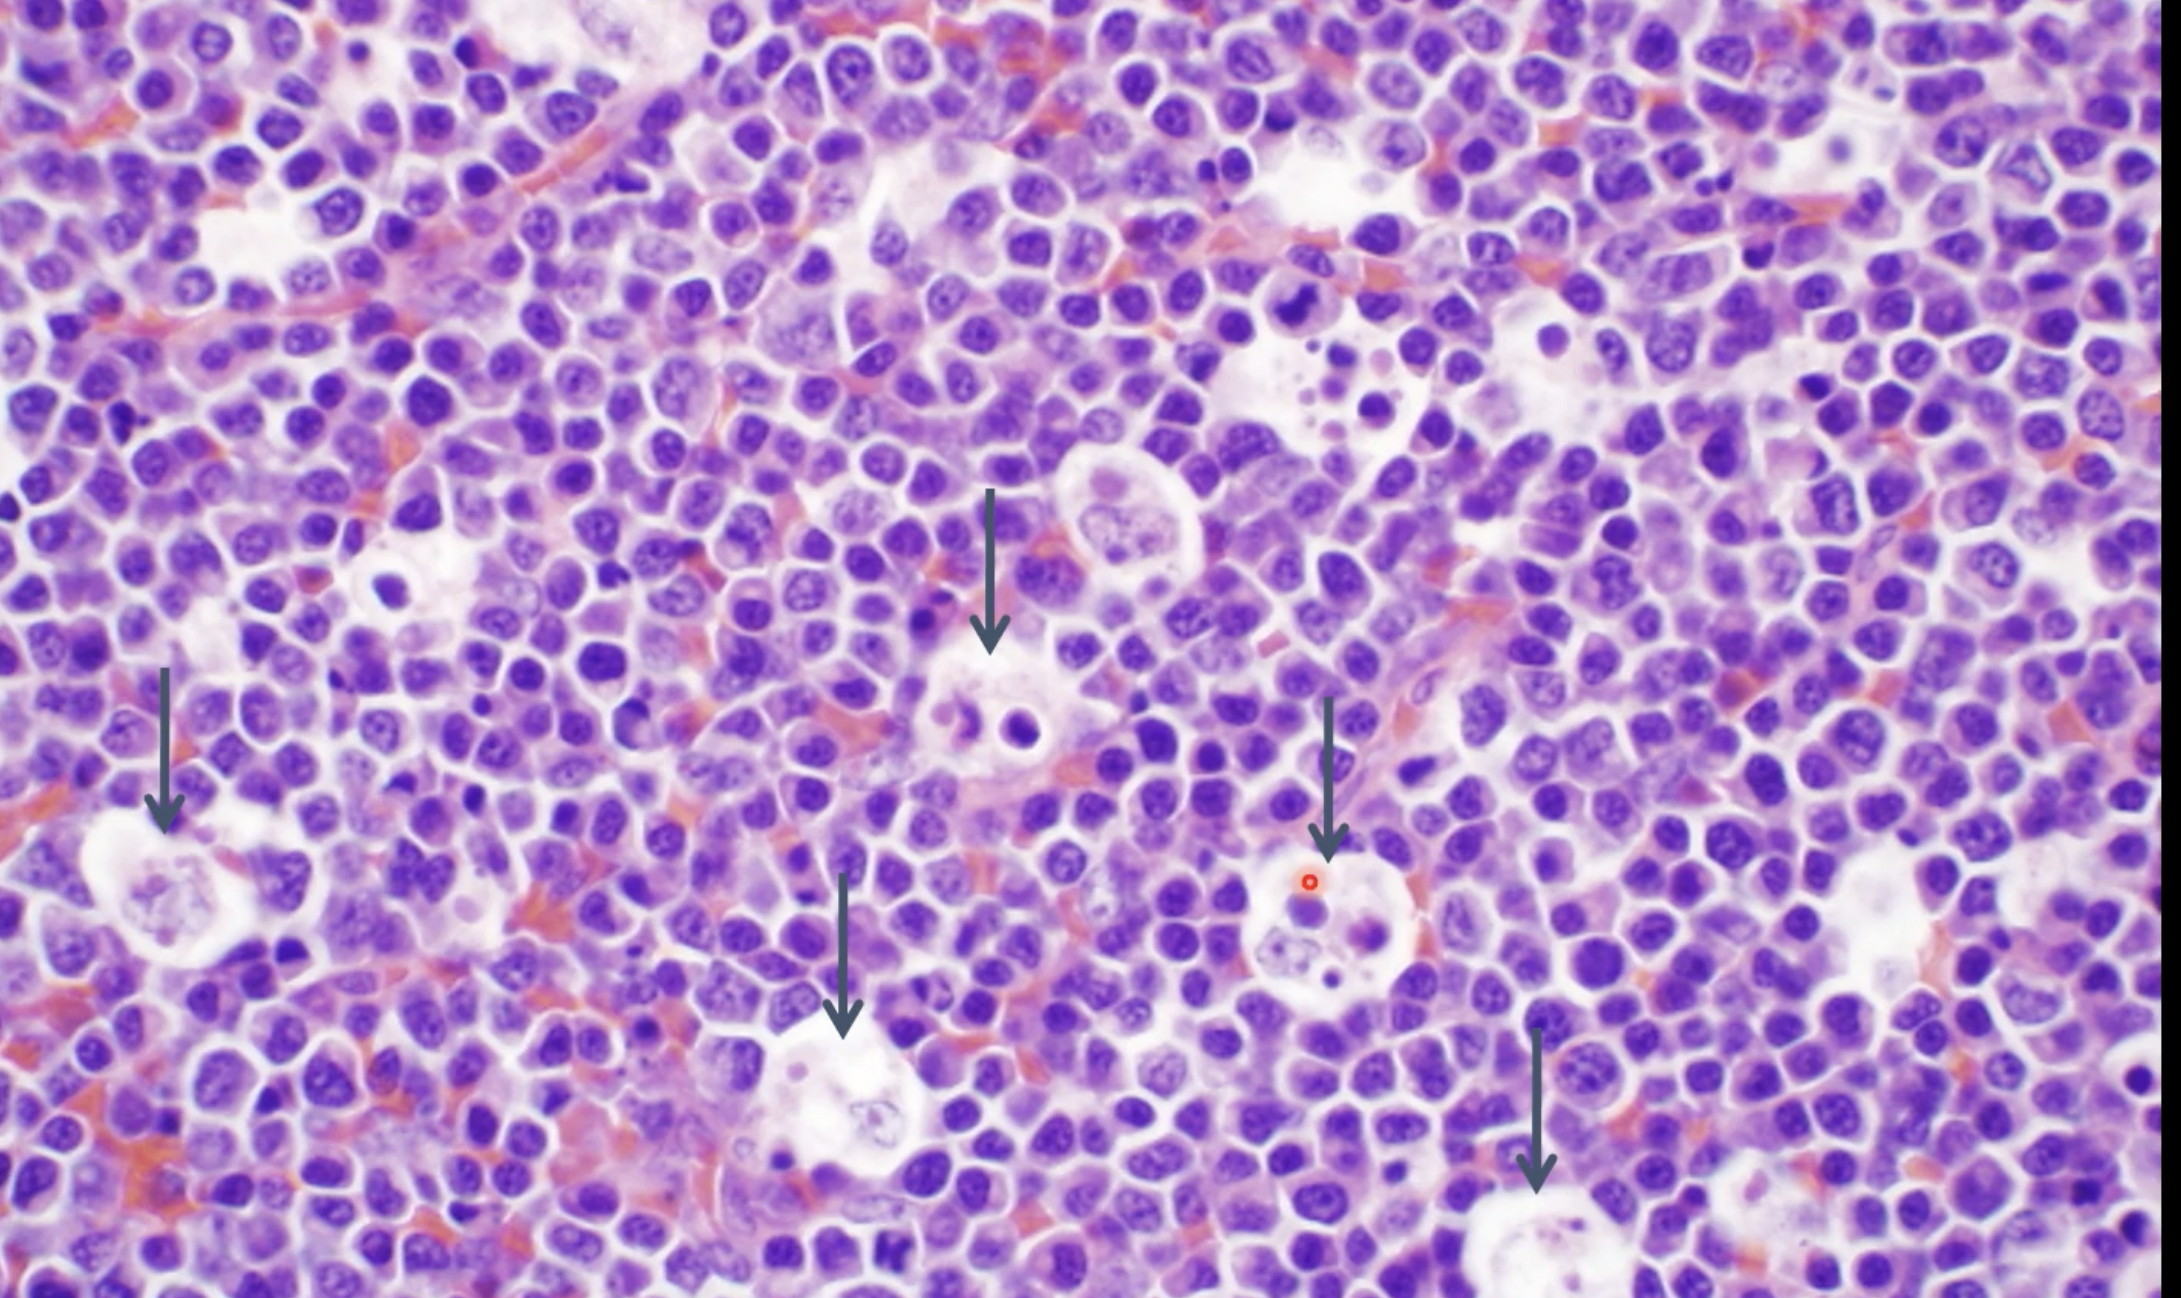
term image

necrosis and apoptosis - work load adaptation
1/78
Earn XP
Description and Tags
lecture 6
Name | Mastery | Learn | Test | Matching | Spaced | Call with Kai |
|---|
No analytics yet
Send a link to your students to track their progress
79 Terms
Cellular swelling is one of the most common and basic signs of cell
injury. Which specific process causes this event?
a.) Multiplication of mitochondria due to increased demands on the cell.
b.) Storage of pigment in cells.
c.) Loss of Na+/K+ ATPase function
c.) Loss of Na+/K+ ATPase function
for coagulation necrosis, the outline of the cell persists because there is denaturation of protein ncluding enzymes, thus
self digestion via these enzymes cannot occur and the cellular components are not dissolved until the arrival of inflammatory cells
cytoplasmic changes in dead cells involve
loss of differential staining of nucleus and cytoplasm (hypereosinophilic)
swelling with fragmentation
loss of cell to cell contact
loss of microvilli and cilia

which side is exhibiting necrotic hepatocytes?
left side
liquefactive necrosis occurs when
enzymatic digestion of necrotic cells predominates
for liquefactive necrosis in bacterial infections, neutrophils contain
potent hydrolases
liquefactive necrosis occurs in hypoxic damage of the
CNS
what is the gross appearance of liquefactive necrosis?
soft, viscous, fluid mass
in acute inflammation, liquid is mostly dead WBC (pus)
what is the microscopic appearance of liquefactive necrosis?
may see degenerate neutrophils and/or amorphous necrotic material
(or nothing if necrotic tissue has flowed out)
caseous necrosis is seen with specific bacterial diseases like
tuberculosis, caseous lymphadenitis
what is the gross appearance of caseous necrosis?
grey-white, dry (inspissated),
friable to pasty necrotic material
cheese like
frequently with dystrophic calcification
with the microscopic appearance of caseous necrosis, dead cells persist as
amorphous, coarsely, granular eosinophilic debris
with the microscopic appearance of caseous necrosis, necrotic cells do not
retain cellular outline
undergo complete dissolution
the microscopic appearance of caseous necrosis is frequently associated with
granulomatous inflammation and thick outer fibrous capsule
gangrenous necrosis is defined as
ischemic necrosis of extremities, such as limbs, digits, or tips of ears
what are examples of gangrenous inflammation
aspiration pneumonia and gangrenous mastitis
dry gangrene
coagulation of necrosis of an extremity with subsequent mummification
wet gangrene
when the coagulative necrosis of dry gangrene is modifidied by the liquefactive action of saprophytic/putrefactive bacteria
gas (emphysematous) gangrene
clostridial infections with necrosis and gas production
eg C. chauvoei (blackleg)
fact necrosis is distinguished by its
location in body fat stores
what is the etiology of fat necrosis
inflammation, vit E deficiency, trauma, idiopathic
what is the gross appearance of fat necrosis
firm to hard, white/chaky ± gritty area (oftens adjacent to normal fat - saponification)
what is the microscopic appearance of fat necrosis
often see basophilic calcium deposits and often surrounded by inflammatory cells
is necrosis or apoptosis active (1)
apoptosis (1)
does necrosis or apoptosis have a tissue respone (2)
necrosis (2)
necrosis causes ______ ______, while apoptosis causes _____ ______-
membrane injury
DNA damage
between necrosis and apoptosis, which one does not have mitochondrial and ER changes (3)
apoptosis (3)
between necrosis and apptosis, which has blebbing only? (4)
apoptosis (4)
does necrosis or apoptosis have karyolysis (5)
necrosis (5)
apoptosis lacks which one
pyknosis
karyorrhexis
karyolysis
karyolysis
apoptosis will have ______ cytoplasmic eosinophila
increased
apoptosis results in the formation of
apoptotic bodies
what are apoptotic bodies
cell fragments bounded by plasma membrane containing normal organelles and condensed nuclear fragments
what are the 5 causes of apoptosis?
cell death during embryogenesis
normal turnover
immune system
cell death in neoplasm
pathogenic stimuli
What are examples of normal turnover that causes apoptosis?
hormone dependent involution
cell deletion in proliferating population
What are examples of the immune system causing apoptosis?
deletion of autoreactive T cell clones in thymus
cell death of cytokine-starved lymphocytes
cell death induced by cytotoxic T cells
what are examples of pathogenic stimuli that cause apoptosis?
some viruses and immune-mediated processes
radiation/drugs damaging DNA
low doses of toxins/drugs, hyperthermia, hypoxia
what is the morphology of apoptosis
cell shrinkage
chromatin condensation
cytoplasmic blebs → apoptotic bodies
phagocytosis of apoptotic bodies
who performs phagocytosis of apoptotic bodies
macrophages with no inflammation
erythema multiforme is defined as the
Acute reaction pattern of the skin and mucous membranes that may be
elicited by a wide array of trigger factors
even though the pathogenesis of erythema multiforme is incompletely understood, what is the hypothesis?
EM represents a T lymphocyte mediated hypersensitivity reaction directed towards various antigens
Erythema Multiforme is considered rare in ____ and is most commonly associated with
dogs
drug administration and infections
rare cases of erythema multiforme is associated with
diet
some cases of EM are considered ________
idiopathic
atrophy
when cells are no longer stimulated (needed)
(Aplasia/hypoplasia: congenital defect in which the organ
was not or only insufficiently formed)
caused decreased size of organ or tissue
Hypertrophy/Hyperplasia
when cells are over-stimulated
metaplasia
reversible; replacement of one adult cell type
(more specialized) by another cell type of the same germ
line (less specialized)
dysplasia
abnormality in maturation of cells within a tissue
(usually epithelial cells); often indicative of early neoplastic
process
hypoplasia
an organ or tissue that never reaches full size
where is hypoplasia often seen
in young animals
physiologic atrophy is also known as
known as involution
physiologic atrophy happens in
fetal development
thymus atrophy/atrophy of lymphoid tissue
senile atrophy
age-independent atrophy
why is senile atrophy called “brown atrophy”
due to intracellular “lipofuscin” accumulation
age-independent atrophy is cycle-dependent and known as
involution of uterus and mammary gland post partum
pathologic atrophy is NOT the same as
involution
what are the two types of pathologic atrophy
localized and generalized
localized pathologic atrophy includes
disuse,
neurogenic
ischemic
compression/pressure
nerve cell atrophy
types of nerve cell atrophy
retrograde, prograde, and Wallerian
what are the types of generalized pathologic atrophy
inanition and systemic
What are the two mechanisms for atrophy
lysosomal acid hydrolases (cathepsin)
ubiquitin-proteasome pathway
atrophy: cytosolic and nuclear proteins conjugated to “ubiquitin” →
degradation within a large cytoplasmic organelle: “proteasome
atrophy is often accompanied by increased numbers of
autophagic vacuoles
in atrophy: if not digestible →
membrane bound residual bodies remain (eg lipofuscin)

what is this?
rim of hyperemia in dog brain - liquefactive necrosis

what is this?
melting of tissue in spinal vertebrae with pus present - liquefactive necrosis

what is this
mammary gland from bovine with demarcated tissue and pus present - liquefactive necrosis

what is happening?
lymphoid effaced by cheese-like material - caseous necrosis

what is happening
lymph node in goat - caseous lymphadenitis, effaces normal tissue and white areas are gritty - caseous necrosis

large glomerulations of macrophages - caseous necrosis

dry gangrene on ear tips of sow
what is another common cause of dry or wet gangrene
frostbite

aspiration pneumonia - gangrenous necrosis; plant material stuck in lung

pancreatitis in dogs - fat necrosis; pancreas leaks lipase causing fat tissue necrosis - evidenced by the white tissue.

firm fat has turned into soapy mineralized material (like saponification) in cow - fat necrosis

adipocytes develop wispy blue material in fat necrosis
apoptosis of lymphocytes

apoptotic cells are shrunken causing crusting around the area


compression atrophy - cerebrum of cat that had blockage of ventricular system and causes CSF build up

horse; damage to recurrent laryngeal nerve, cricoarytenoid muscles has atrophy on one side